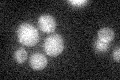
YNL255C
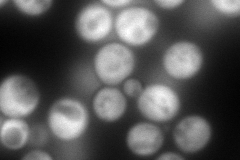
YNL255C
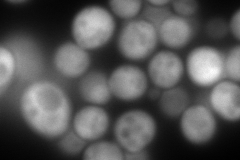
YNL255C
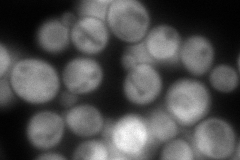
YNL255C
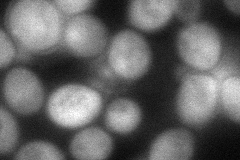
YNL255C
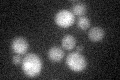
YNL255C

View description
Protein with seven cysteine-rich CCHC zinc-finger motifs, similar to human CNBP, proposed to be involved in the RAS/cAMP signaling pathway
Localization:
Intensity:
Fold change:
Significance:
-
C’ GFP library in SD
below threshold17.78 -
N' NOP1pr-GFP in SD
cytosol341.006 -
N' TEF2pr-mCherry in SD
cytosol516.836 -
N' NATIVEpr-GFP in SD
cytosol304.302 -
N' TEF2pr-VC and Cyto-VN in SD
cytosol81.6306 -
C’ GFP library in SD+DTT
cytosol16.920.95No -
C’ GFP library in SD+H2O2

cytosol15.780.88No -
C’ GFP library in Starvation Media

cytosol17.360.97No -
C’ GFP library on the background of Pup2-DaMP

below threshold -
C’ GFP library on the background of CCT mutant

below threshold16.28760.915691No
